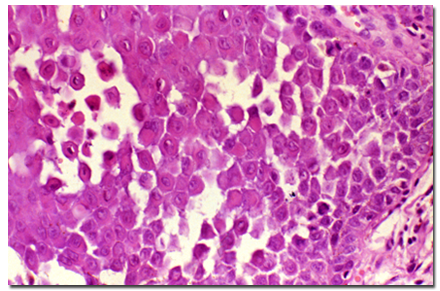

![]()

口腔黏膜由上皮及上皮下结缔组织构成,其结构与皮肤基本相似,上皮相当于皮肤的表皮,固有层与黏膜下层相当于皮肤的真皮。上皮借基底膜与固有层相连。发生于口腔黏膜的疾病,其病变皆出现在上皮层、基底层或上皮下结缔组织。
本节重点介绍以下二十种口腔黏膜病的基本病理变化。
【过度角化】
过度角化(hyperkeratosis)也称角化亢进,是指黏膜或皮肤的角化层过度增厚,临床上为乳白色或灰白色。在组织学上可分为过度正角化(hyper- orthokeratosis)和过度不全角化(hyperparakeratosis)两种。过度正角化是角化层增厚,细胞界限不清,细胞核消失,形成均匀性嗜伊红染色的角化物,伴有粒层增厚且透明角质颗粒异常明显;过度不全角化为增厚的角化层中胞核未分解消失,粒层增厚不明显。

【角化不良】
角化不良(dyskeratosis)也称错角化,为上皮的异常角化,在上皮棘层或基底层内个别或一群细胞发生角化。角化不良有两种情况:一为良性角化不良,多在高度增生的上皮钉突中出现;另一种为恶性角化不良,有时可见胞核,细胞形态有一定异型性,见于原位癌及鳞状细胞癌。

【棘层增生】
棘层增生(acanthosis)为棘细胞层较正常肥厚,增厚的棘层常不规则,伴有上皮钉突的延长或增宽。棘层的肥厚可由于棘层细胞的肥大或细胞数目增加所致,但通常是由于细胞数目增加所致。此病变常见于白斑。

【上皮异常增生】
上皮异常增生(epithelial dysplasia)和细胞非典型增生是两个词,为WHO(1978、1996)口腔癌和癌前病变研究中心提出:个别细胞改变称为非典型性(atypical),上皮总的紊乱称为上皮异常增生。
上皮异常增生可发生以下变化: ★ 上皮基底细胞极性消失;
★ 上皮基底细胞极性消失;
★ 出现一层以上基底样细胞;
★ 核浆比例增加;
★ 上皮钉突呈滴状;
★ 上皮层次紊乱;
★ 有丝分裂像增加,可见少数异常有丝分裂;
★ 上皮浅表1/2出现有丝分裂;
★ 细胞多形性;
★ 细胞核浓染;
★ 核仁增大;细胞黏着力下降;在棘细胞层中单个或成团细胞角化。并不是以上12项均出现才诊断为上皮异常增生,根据以上项目出现的数目,而分为轻、中、重度上皮异常增生。
【上皮萎缩】
上皮萎缩(epithelial atrophy)主要是指上皮棘层细胞数量减少,致使上皮层变薄。可见于慢性盘状红斑狼疮及扁平苔藓等病。
【海绵形成】

海绵形成(spongiosis)为上皮细胞间由于水肿液聚积,细胞间隙加宽,棘细胞间桥拉长或断裂,这种病变图像很似海绵,常见于黏膜炎症。
【基底细胞空泡性变及液化】
基底细胞空泡性变及液化(vaculation and liquefaction of basal cell)为基底细胞内水肿,较轻时细胞稍增大,胞浆呈空泡状,称空泡性变;水肿严重时,基底细胞即发生液化溶解破碎,基底细胞排列不齐,基底膜不清,甚至消失。此种病变常见于扁平苔藓和红斑狼疮。

【气球样变】

气球样变(ballooning degeneration)为上皮细胞内水肿,体积明显增大变圆色浅,故称气球样变,见于病毒性黏膜病。
【网状变性】
网状变性(reticular degeneration)为上皮细胞由于严重的细胞内水肿,部分细胞破裂,残存的细胞壁相互连接成网状,网眼内充满水肿液,严重时形成多房性水疱。此病变见于病毒感染的疾患,如单纯疱疹、疱疹性口炎等。

【细胞凋亡】
细胞凋亡(cell apoptosis)又称程序化细胞死亡(programmed cell death),是一种受基因控制的主动性细胞自杀过程,为生理性细胞死亡的一种形式。其表现为细胞皱缩,胞浆嗜酸深染,胞核染色质边聚,细胞间失去连接,核碎裂后形成凋亡小体,周围无炎症反应。
【棘层松解】
棘层松解(acantholysis)是由于上皮棘层细胞间张力原纤维及黏合物质发生变性、断裂破坏,细胞间桥溶解,而使棘细胞间联系力松弛、断裂,严重时失去联系,解离,则在棘层形成裂隙或疱。此种病变见于天疱疮等。
【疱】
疱(vesicle)为黏膜或皮肤内贮存液体而成疱。疱的内容物有浆液(水疱)、血液(血疱)及脓液(脓疱)。疱凸出于黏膜,表面呈半圆形,周围有的有红晕。疱的大小不一,小的肉眼仅可看出,大的如豌豆般大或更大一些,也可相互融合在一起,一般直径超过5 mm者称大疱(bulla)。小的水疱直径在1~3mm,若聚集成簇,称为疱疹。口腔黏膜的疱由于经常接受机械刺激,所以疱形成后很快破裂,且不结痂皮,是由于口腔内经常有唾液湿润的缘故。
在组织学上根据疱形成的部位可分:

★ 棘层内疱 疱在上皮棘层内或在基底层上,有棘层松解,上皮细胞失去内聚力而分离。见于天疱疮,也见于病毒性水疱。
★ 基层下疱 疱在基底层之下,基底细胞变性,使上皮全层剥离,见于黏膜良性类天疱疮、多形渗出性红斑。
【糜烂】
糜烂(erosion)为上皮浅层破坏,未侵犯上皮全层称糜烂。可由机械刺激或药物烧伤而引起,也可继发于水疱破溃后,如疱疹。糜烂面一般鲜红,表面平滑而湿润,可有疼痛。以后由上皮细胞增生而痊愈,并不遗留瘢痕。
【溃疡】
溃疡(ulcer)是黏膜或皮肤表层坏死而脱落形成凹陷为溃疡。按其破坏组织的程度,可分为浅层溃疡和深层溃疡。浅层溃疡只破坏上皮层,愈合后不留瘢痕,如复发性阿弗他溃疡。而深层溃疡则病变波及黏膜下层,痊愈后遗留瘢痕,如复发性坏死性黏膜腺周围炎。
溃疡是多种多样的,大小、数目、深浅均不一。检查溃疡时要注意边缘是否整齐,有无倒凹;溃疡面有无假膜形成;底部是平坦,还是有颗粒结节;基底部有无硬结;是否向周围浸润。这些现象对于确定诊断及分析黏膜病特别是早期发现恶性病变都很重要。
【皲裂】

皲裂(rhagade)是黏膜或皮肤发生的线状裂口称为皲裂,系由某些疾病或炎性浸润使组织失去弹力变脆而成,如核黄素缺乏时可引起皲裂。
当皲裂较浅时,仅限于黏膜的上皮层时容易愈合而不遗留瘢痕;当皲裂较深已达黏膜下层时,能使黏膜出血及引起灼痛,愈合时形成瘢痕。
【假膜】

假膜(pseudomembrane)也称伪膜,为灰白色或黄白色的膜。在溃疡的表面常有假膜形成,假膜由炎症渗出的纤维素形成网架,将坏死脱落的上皮细胞和炎症渗出的细胞聚集在一起而形成。假膜不是组织本身,所以能擦掉或撕脱,不过在不同疾病或疾病的不同阶段撕脱有难易之分。而黏膜的角化病变也为白色但不能撕脱,因此,在临床上可以将假膜与白斑等角化情况区别。
【斑】
斑(macule)是黏膜或皮肤上的颜色异常,范围一般较局限,大小不等,不高起,不变厚,也无硬度的改变,可为暂时性或永久性。红色斑为黏膜固有层血管增生、扩张及充血。临床上为了区别皮肤或黏膜红色斑是充血还是出血,可用玻片压迫法。如加压后透过玻片的血色消失,则说明是充血,如加压后仍有血色,则说明是出血。

黑斑可由于上皮基底层的黑色素细胞增多;也可由于黏膜固有层有噬黑色素细胞(melanophages)存在;或含铁血黄素存在;黏膜内有某些金属颗粒沉积也可形成黑斑,如银汞沉着症,在吞噬细胞内、血管壁的嗜银膜及上皮的基底膜上均见棕黑色的细小颗粒。
【丘疹】

丘疹(papule)是黏膜或皮肤上凸出的小疹,大小为1~5 mm,较硬,色灰或发红,消失后不留痕迹。丘疹的基底为圆形或椭圆形,顶端有尖、圆、扁平各形不一。在麻疹患者往往在颊黏膜出现丘疹,为诊断该病的一个早期特征。
丘疹在显微镜下表现为:
★ 上皮增厚;
★ 浆液渗出;
★ 炎症细胞浸润。
【嗜碱性变】
嗜碱性变(basophilic degeneration)是一种胶原纤维的变性、膨胀、断裂,形成无定形弱嗜碱性排列不规则的纤维团块或颗粒,HE染色呈浅灰蓝色。这些变性的胶原纤维与上皮之间常有一狭窄的未变性的胶原带。这种病变常见于老年性变性、老年性角化病、红斑狼疮、日光性唇炎等。

【痂】
痂(crusts)通常发生于皮肤。口腔主要发生于唇红部,多为黄白色的痂皮,如伴有出血,则呈深红褐色。其成分主要为纤维素性渗出以及炎症性渗出的混合物,常与上皮或表皮的表层粘连在一起凝固而成。
-----------------------------------------------------------------------------------------



